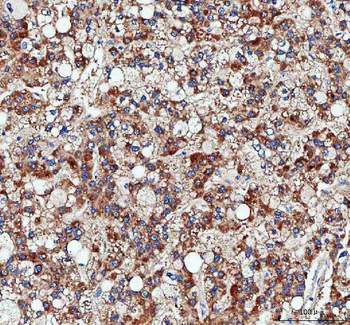
Pyruvate Carboxylase/PC Rabbit Polyclonal Antibody

You have no items in your shopping cart.
Pyruvate Carboxylase/PC Rabbit Polyclonal Antibody
Description
Research Area
Images & Validation
−| Tested Applications | ELISA, FC, ICC, IF, IHC, WB |
|---|---|
| Dilution Range | Western blot, 0.1-0.25 μg/ml, Human, Mouse, Rat Immunohistochemistry (Paraffin-embedded Section), 2-5 μg/ml, Human, Mouse, Rat Immunocytochemistry/Immunofluorescence, 5 μg/ml, Human Flow Cytometry (Fixed), 1-3 μg/1x10^6 cells, Human ELISA, 0.1-0.5 μg/ml, - |
| Reactivity | Human, Mouse, Rat |
Key Properties
−| Antibody Type | Primary Antibody |
|---|---|
| Host | Rabbit |
| Clonality | Polyclonal |
| Isotype | IgG |
| Immunogen | E.coli-derived human Pyruvate Carboxylase/PC recombinant protein (Position: R88-D1165). Human PC shares 97% and 96.6% amino acid (aa) sequence identity with mouse and rat PC, respectively. |
| Target | Pyruvate carboxylase, mitochondrial |
| Molecular Weight | 125 kDa |
| Purification | Immunogen affinity purified. |
| Conjugation | Unconjugated |
Storage & Handling
−| Storage | Maintain refrigerated at 2-8°C for up to 2 weeks. For long term storage store at -20°C in small aliquots to prevent freeze-thaw cycles. |
|---|---|
| Form/Appearance | Lyophilized |
| Buffer/Preservatives | Each vial contains 4 mg Trehalose, 0.9 mg NaCl, 0.2 mg Na2HPO4. |
| Concentration | Adding 0.2 ml of distilled water will yield a concentration of 500 μg/ml. |
| Expiration Date | 12 months from date of receipt. |
| Disclaimer | For research use only |
Alternative Names
−Similar Products
−Pyruvate Carboxylase/PC Rabbit Polyclonal Antibody (APC) [orb2584765]
FC
Human, Mouse, Rat
Rabbit
Polyclonal
APC
100 μgPyruvate Carboxylase/PC Rabbit Polyclonal Antibody (FITC) [orb2584767]
FC
Human, Mouse, Rat
Rabbit
Polyclonal
FITC
100 μgPyruvate Carboxylase/PC Rabbit Polyclonal Antibody (Cy3) [orb2584768]
FC
Human, Mouse, Rat
Rabbit
Polyclonal
Cy3
100 μgPyruvate Carboxylase/PC Rabbit Polyclonal Antibody (Biotin) [orb2584769]
ELISA, IHC, WB
Human, Mouse, Rat
Rabbit
Polyclonal
Biotin
100 μgPyruvate Carboxylase/PC Rabbit Polyclonal Antibody (PE) [orb2584764]
FC
Human, Mouse, Rat
Rabbit
Polyclonal
PE
100 μg

Quality Guarantee
Explore bioreagents carefree to elevate your research. All our products are rigorously tested for performance. If a product does not perform as described on its datasheet, our scientific support team will provide expert troubleshooting, a prompt replacement, or a refund. For full details, please see our Terms & Conditions and Buying Guide. Contact us at support@biorbyt.com.

IHC analysis of Pyruvate Carboxylase/PC using anti-Pyruvate Carboxylase/PC antibody. Pyruvate Carboxylase/PC was detected in a paraffin-embedded section of mouse kidney tissue. Heat mediated antigen retrieval was performed in EDTA buffer (pH8.0, epitope retrieval solution). The tissue section was blocked with 10% goat serum. The tissue section was then incubated with 2 µg/ml rabbit anti-Pyruvate Carboxylase/PC Antibody overnight at 4°C. Peroxidase Conjugated Goat Anti-rabbit IgG was used as secondary antibody and incubated for 30 minutes at 37°C. The tissue section was developed using HRP Conjugated Rabbit IgG Super Vision Assay Kit with DAB as the chromogen.

Flow Cytometry analysis of MCF-7 cells using anti-Pyruvate Carboxylase/PC antibody. Overlay histogram showing MCF-7 cells (Blue line). To facilitate intracellular staining, cells were fixed with 4% paraformaldehyde and permeabilized with permeabilization buffer. The cells were blocked with 10% normal goat serum. And then incubated with rabbit anti-Pyruvate Carboxylase/PC Antibody (1 µg/1x10^6 cells) for 30 min at 20°C. DyLight®488 conjugated goat anti-rabbit IgG (5-10 µg/1x10^6 cells) was used as secondary antibody for 30 minutes at 20°C. Isotype control antibody (Green line) was rabbit IgG (1 µg/1x10^6) used under the same conditions. Unlabelled sample (Red line) was also used as a control.

IF analysis of Pyruvate Carboxylase/PC using anti-Pyruvate Carboxylase/PC antibody. Pyruvate Carboxylase/PC was detected in an immunocytochemical section of HELA cells. Enzyme antigen retrieval was performed using IHC enzyme antigen retrieval reagent for 15 mins. The cells were blocked with 10% goat serum. And then incubated with 5 µg/mL rabbit anti-Pyruvate Carboxylase/PC Antibody overnight at 4°C. DyLight®488 Conjugated Goat Anti-Rabbit IgG was used as secondary antibody at 1:500 dilution and incubated for 30 minutes at 37°C. The section was counterstained with DAPI. Visualize using a fluorescence microscope and filter sets appropriate for the label used.

IHC analysis of Pyruvate Carboxylase/PC using anti-Pyruvate Carboxylase/PC antibody. Pyruvate Carboxylase/PC was detected in a paraffin-embedded section of human bladder urothelial carcinoma tissue. Heat mediated antigen retrieval was performed in EDTA buffer (pH8.0, epitope retrieval solution). The tissue section was blocked with 10% goat serum. The tissue section was then incubated with 2 µg/ml rabbit anti-Pyruvate Carboxylase/PC Antibody overnight at 4°C. Peroxidase Conjugated Goat Anti-rabbit IgG was used as secondary antibody and incubated for 30 minutes at 37°C. The tissue section was developed using HRP Conjugated Rabbit IgG Super Vision Assay Kit with DAB as the chromogen.
IHC analysis of Pyruvate Carboxylase/PC using anti-Pyruvate Carboxylase/PC antibody. Pyruvate Carboxylase/PC was detected in a paraffin-embedded section of human liver cancer tissue. Heat mediated antigen retrieval was performed in EDTA buffer (pH8.0, epitope retrieval solution). The tissue section was blocked with 10% goat serum. The tissue section was then incubated with 2 µg/ml rabbit anti-Pyruvate Carboxylase/PC Antibody overnight at 4°C. Peroxidase Conjugated Goat Anti-rabbit IgG was used as secondary antibody and incubated for 30 minutes at 37°C. The tissue section was developed using HRP Conjugated Rabbit IgG Super Vision Assay Kit with DAB as the chromogen.

IHC analysis of Pyruvate Carboxylase/PC using anti-Pyruvate Carboxylase/PC antibody. Pyruvate Carboxylase/PC was detected in a paraffin-embedded section of human lung adenocarcinoma tissue. Heat mediated antigen retrieval was performed in EDTA buffer (pH8.0, epitope retrieval solution). The tissue section was blocked with 10% goat serum. The tissue section was then incubated with 2 µg/ml rabbit anti-Pyruvate Carboxylase/PC Antibody overnight at 4°C. Peroxidase Conjugated Goat Anti-rabbit IgG was used as secondary antibody and incubated for 30 minutes at 37°C. The tissue section was developed using HRP Conjugated Rabbit IgG Super Vision Assay Kit with DAB as the chromogen.

IHC analysis of Pyruvate Carboxylase/PC using anti-Pyruvate Carboxylase/PC antibody. Pyruvate Carboxylase/PC was detected in a paraffin-embedded section of rat kidney tissue. Heat mediated antigen retrieval was performed in EDTA buffer (pH8.0, epitope retrieval solution). The tissue section was blocked with 10% goat serum. The tissue section was then incubated with 2 µg/ml rabbit anti-Pyruvate Carboxylase/PC Antibody overnight at 4°C. Peroxidase Conjugated Goat Anti-rabbit IgG was used as secondary antibody and incubated for 30 minutes at 37°C. The tissue section was developed using HRP Conjugated Rabbit IgG Super Vision Assay Kit with DAB as the chromogen.

Western blot analysis of Pyruvate Carboxylase/PC using anti-Pyruvate Carboxylase/PC antibody. Electrophoresis was performed on a 5-20% SDS-PAGE gel at 70V (Stacking gel) / 90V (Resolving gel) for 2-3 hours. The sample well of each lane was loaded with 30 ug of sample under reducing conditions. Lane 1: human HepG2 whole cell lysates, Lane 2: human Hela whole cell lysates, Lane 3: human SiHa whole cell lysates, Lane 4: rat liver tissue lysates, Lane 5: rat RH35 whole cell lysates, Lane 6: mouse liver tissue lysates. After electrophoresis, proteins were transferred to a nitrocellulose membrane at 150 mA for 50-90 minutes. Blocked the membrane with 5% non-fat milk/TBS for 1.5 hour at RT. The membrane was incubated with rabbit anti-Pyruvate Carboxylase/PC antigen affinity purified polyclonal antibody at 0.25 µg/mL overnight at 4°C, then washed with TBS-0.1% Tween 3 times with 5 minutes each and probed with a goat anti-rabbit IgG-HRP secondary antibody at a dilution of 1:5000 for 1.5 hour at RT. The signal is developed using an Enhanced Chemiluminescent detection (ECL) kit with Tanon 5200 system. A specific band was detected for Pyruvate Carboxylase/PC at approximately 125 kDa. The expected band size for Pyruvate Carboxylase/PC is at 130 kDa.
Quick Database Links
UniProt Details
−Documents Download
Request a Document
Protocol Information
Pyruvate Carboxylase/PC Rabbit Polyclonal Antibody (orb1819442)
Participating in our Biorbyt product reviews program enables you to support fellow scientists by sharing your firsthand experience with our products.
Login to Submit a Review